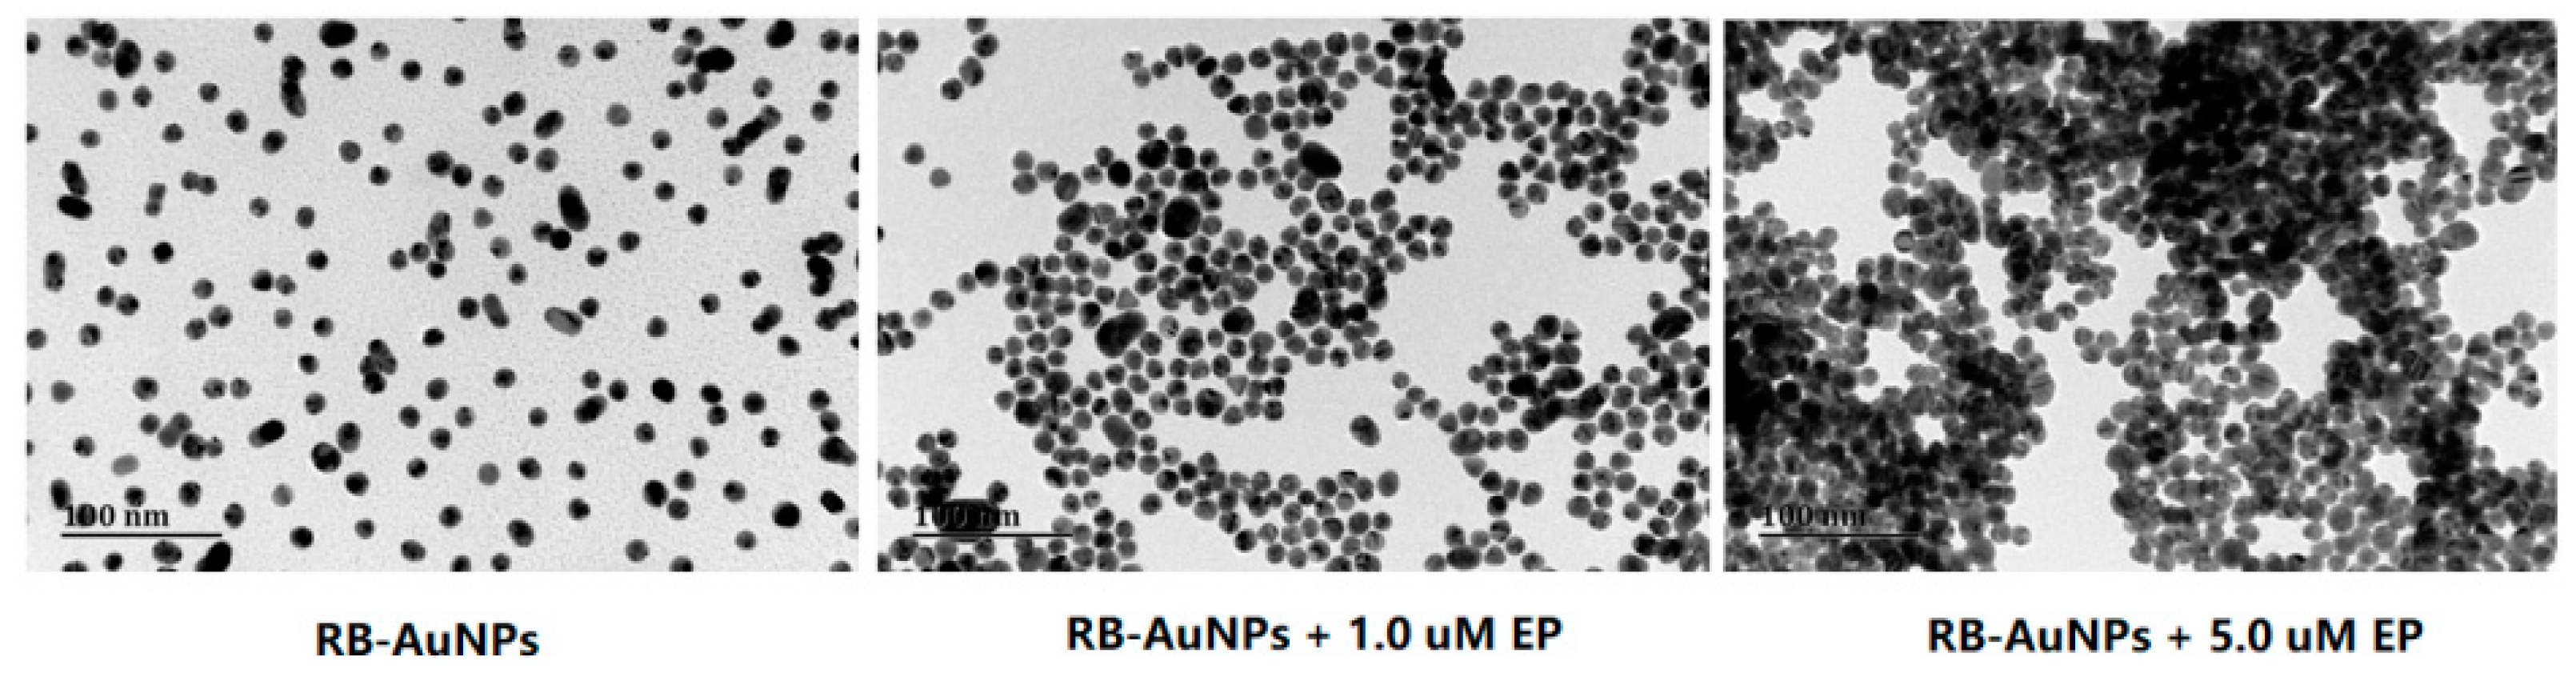
Sensors 18 04302 g004 Sensors 18 04302 g004

A Simple Colorimetric and Fluorescent Sensor to Detect Organophosphate Pesticides Based on Adenosine Triphosphate-Modified Gold Nanoparticles
Abstract
1. Introduction
2. Materials and Methods
2.1. Chemicals and Instruments
2.2. Preparation of Stock Solutions
2.3. Preparation of AuNPs
2.4. Citrate-Capped Hydrophilic AuNPs
2.5. Preparation of ATP-Modified AuNPs and Rhodamine B-Coated AuNPs
2.6. Citrate-Capped AuNPs Pesticide Assay
2.7. ATP-Protected AuNPs Pesticide Assay
2.8. Experimental Procedure for Ethoprophos Detection Sensitivity
3. Results and Discussion
3.1. Aggregation-Inducing Effect of OPs on Citrate-Capped AuNPs
3.2. C.olorimetric and Fluorescent Detection of OPs by RB-AuNPs
3.3. The Effect of ATP Concentration on OP Detection by RB-AuNPs
3.4. The pH Effect on the Colorimetric Assay for Ethoprophos
3.5. Mechanism for Ethoprophos Detection
3.6. Ethoprophos LOD in RB-AuNPs
3.7. Ethoprophos Detection in Real Samples
4. Conclusions
Author Contributions
Funding
Conflicts of Interest
References
- Mogul, M.G.; Akin, H.; Hasirci, N.; Trantolo, D.J.; Gresser, J.D.; Wise, D.L. Controlled Release of Biologically Active Agents for Purposes of Agricultural Crop Management. Resour. Conserv. Recycl. 1996, 16, 289–320. [Google Scholar] [CrossRef]
- International Code of Conduct on the Distribution and Use of Pesticides; Food and Agriculture Organization of the United Nations: Rome, Italy, 2007.
- Lamberth, C.; Jeanmart, S.; Luksch, T.; Plant, A. Current Challenges and Trends in the Discovery of Agrochemicals. Science 2013, 341, 742–746. [Google Scholar] [CrossRef] [PubMed]
- Grube, A.; Donaldson, D.; Kiely, T.; Wu, L. Pesticides Industry Sales and Usage; U.S. Environmental Protection Agency: Washington, DC, USA, 2011.
- Jamal, G.A. Neurological syndromes of organophosphorus compounds. Toxicol. Rev. 1997, 16, 133–170. [Google Scholar]
- Roast, S.D.; Thompson, R.S.; Donkin, P.; Widdows, J.; Jones, M.B. Toxicity of the organophosphate pesticides chlorpyrifos and dimethoate to Neomysis integer (Crustacea: Mysidacea). Water Res. 1999, 33, 319–326. [Google Scholar] [CrossRef]
- Dawson, A.H.; Eddleston, M.; Senarathna, L.; Mohamed, F.; Gawarammana, I.; Bowe, S.J.; Manuweera, G.; Buckley, N.A. Acute Human Lethal Toxicity of Agricultural Pesticides: A Prospective Cohort Study. PLoS Med. 2010, 7, e1000357. [Google Scholar] [CrossRef] [PubMed]
- Battaglin, W.; Fairchild, J. Potential toxicity of pesticides measured in midwestern streams to aquatic organisms. Water Sci. Technol. 2002, 45, 95–102. [Google Scholar] [CrossRef] [PubMed]
- Kim, K.; Tsay, O.G.; Atwood, D.A.; Churchill, D.G. Destruction and Detection of Chemical Warfare Agents. Chem. Rev. 2011, 111, 5345–5403. [Google Scholar] [CrossRef]
- Aragay, G.; Pino, F.; Merkoci, A. Nanomaterials for Sensing and Destroying Pesticides. Chem. Rev. 2012, 112, 5317–5338. [Google Scholar] [CrossRef]
- Mileson, B.E.; Chambers, J.E.; Chen, W.L.; Dettbarn, W.; Ehrich, M.; Eldefrawi, A.T.; Gaylor, D.W.; Hamernik, K.; Hodgson, E.; Karczmar, A.G.; et al. Common mechanism of toxicity: A case study of organophosphorus pesticides. Toxicol. Sci. 1998, 41, 8–20. [Google Scholar]
- Ray, D.E. Chronic effects of low level exposure to anticholinesterases—A mechanistic review. Toxicol. Lett. 1998, 102, 527–533. [Google Scholar] [CrossRef]
- Eyer, P. The Role of Oximes in the Management of Organophosphorus Pesticide Poisoning. Toxicol. Rev. 2003, 22, 165–190. [Google Scholar] [CrossRef] [PubMed]
- Eddleston, M.; Buckley, N.A.; Eyer, P.; Dawson, A.H. Management of acute organophosphorus pesticide poisoning. Lancet 2008, 371, 597–607. [Google Scholar] [CrossRef]
- Lambropoulou, D.A.; Albanis, T.A. Methods of sample preparation for determination of pesticide residues in food matrices by chromatography–mass spectrometry-based techniques: A review. Anal. Bioanal. Chem. 2007, 389, 1663–1683. [Google Scholar] [CrossRef] [PubMed]
- Zhou, T.; Xiao, X.H.; Li, G.K. Microwave Accelerated Selective Soxhlet Extraction for the Determination of Organophosphorus and Carbamate Pesticides in Ginseng with Gas Chromatography/Mass Spectrometry. Anal. Chem. 2012, 84, 5816–5822. [Google Scholar] [CrossRef] [PubMed]
- Qian, G.L.; Wang, L.M.; Wu, Y.R.; Zhang, Q.; Sun, Q.; Liu, Y.; Liu, F.Q. A monoclonal antibody-based sensitive enzyme-linked immunosorbent assay (ELISA) for the analysis of the organophosphorous pesticides chlorpyrifos-methyl in real samples. Food Chem. 2009, 117, 364–370. [Google Scholar] [CrossRef]
- Viswanathan, S.; Radecka, H.; Radecki, J. Electrochemical biosensor for pesticides based on acetylcholinesterase immobilized on polyaniline deposited on vertically assembled carbon nanotubes wrapped with ssDNA. Biosens. Bioelectron. 2009, 24, 2772–2777. [Google Scholar] [CrossRef] [PubMed]
- Yong, D.M.; Liu, C.; Yu, D.B.; Dong, S.J. A sensitive, rapid and inexpensive way to assay pesticide toxicity based on electrochemical biosensor. Talanta 2011, 84, 7–12. [Google Scholar] [CrossRef] [PubMed]
- Xie, C.G.; Li, H.F.; Li, S.Q.; Wu, J.; Zhang, Z.P. Surface Molecular Self-Assembly for Organophosphate Pesticide Imprinting in Electropolymerized Poly(p-aminothiophenol) Membranes on a Gold Nanoparticle Modified Glassy Carbon Electrode. Anal. Chem. 2010, 82, 241–249. [Google Scholar] [CrossRef]
- Periasamy, A.P.; Umasankar, Y.; Chen, S.M. Nanomaterials—Acetylcholinesterase Enzyme Matrices for Organophosphorus Pesticides Electrochemical Sensors: A Review. Sensors 2009, 9, 4034–4055. [Google Scholar] [CrossRef]
- Klajn, R.; Stoddart, J.F.; Grzybowski, B.A. Nanoparticles functionalised with reversible molecular and supramolecular switches. Chem. Soc. Rev. 2010, 39, 2203–2237. [Google Scholar] [CrossRef]
- Elghanian, R.; Storhoff, J.J.; Mucic, R.C.; Letsinger, R.L.; Mirkin, C.A. Selective Colorimetric Detection of Polynucleotides Based on the Distance-dependent Optical Properties of Gold Nanoparticles. Science 1997, 277, 1078–1081. [Google Scholar] [CrossRef] [PubMed]
- Liu, J.; Lu, Y. A Colorimetric Lead Biosensor Using DNAzyme-Directed Assembly of Gold Nanoparticles. J. Am. Chem. Soc. 2003, 125, 6642–6643. [Google Scholar] [CrossRef] [PubMed]
- Saha, K.; Agasti, S.S.; Kim, C.; Li, X.; Rotello, V.M. Gold Nanoparticles in Chemical and Biological Sensing. Chem. Rev. 2012, 112, 2739–2779. [Google Scholar] [CrossRef] [PubMed]
- Guarise, C.; Pasquato, L.; De Fillippis, V.; Scrimin, P. Gold Nanoparticles-based Protease Assay. Proc. Natl. Acad. Sci. USA 2006, 103, 3978–3982. [Google Scholar] [CrossRef] [PubMed]
- Liu, R.; Liew, R.; Zhou, J.; Xing, B. A Simple and Specific Assay for Real-Time Colorimetric Visualization of β-Lactamase Activity by Using Gold Nanoparticles. Angew. Chem. Int. Ed. 2007, 46, 8799–8803. [Google Scholar] [CrossRef] [PubMed]
- Jiang, T.; Liu, R.; Huang, X.; Feng, H.; Teo, W.; Xing, B. A Gold-Nanoparticel Based Colorimetric Screening Method for Baterial Enzymatic Inhibition. Chem. Comm. 2009, 15, 1972–1974. [Google Scholar] [CrossRef] [PubMed]
- Nam, J.M.; Wise, A.R.; Groves, J.T. Colorimetric Bio-Barcode Amplification Assay for Cytokines. Anal. Chem. 2005, 77, 6985–6988. [Google Scholar] [CrossRef] [PubMed]
- Zhou, W.; Gao, X.; Liu, D.; Chen, X. Gold Nanoparticles for In Vitro Diagnostics. Chem. Rev. 2015, 115, 10575–10636. [Google Scholar] [CrossRef]
- Liu, D.; Chen, W.; Wei, J.; Li, X.; Wang, Z.; Jiang, X. A Highly Sensitive, Dual-Readout Assay Based on Gold Nanoparticles for Organophosphorus and Carbamate Pesticides. Anal. Chem. 2012, 84, 4185–4191. [Google Scholar] [CrossRef]
- Fahimi-Kashani, N.; Hormozi-Nezhad, M.R. Gold-Nanoparticle-Based Colorimetric Sensor Array for Discrimination of Organophosphate Pesticides. Anal. Chem. 2016, 88, 8099–8106. [Google Scholar] [CrossRef]
- Simoniana, A.L.; Goodb, T.A.; Wang, S.; Wild, J.R. Nanoparticle-based optical biosensors for the direct detectionof organophosphate chemical warfare agents and pesticides. Anal. Chim. Acta 2005, 534, 69–77. [Google Scholar] [CrossRef]
- Wu, S.; Li, D.; Wang, J.; Zhao, Y.; Dong, S.; Wang, X. Gold nanoparticles dissolution based colorimetric method for highly sensitive detection of organophosphate pesticides. Sens. Actuator B Chem. 2017, 238, 427–433. [Google Scholar] [CrossRef]
- Turkevich, J.; Stevenson, P.C.; Hillier, J. A study of the nucleation and growth processes in the synthesis of colloidal gold. Discuss. Faraday Soc. 1951, 11, 55–75. [Google Scholar] [CrossRef]
- Alfred, H.E.; Lynn, J.E. Experiments in Colloid Chemistry; McGraw-Hill book Company: New York, NY, USA, 1940. [Google Scholar]
- Opdahl, A.; Petrovykh, D.Y.; Kimura-Suda, H.; Tarlov, M.J.; Whitman, L.J. Independent control of grafting density and conformation of single-stranded DNA brushes. Proc. Natl. Acad. Sci. USA 2007, 104, 9–14. [Google Scholar] [CrossRef]
- Pei, H.; Li, F.; Wan, Y.; Wei, M.; Liu, H.; Su, Y.; Chen, N.; Huang, Q.; Fan, C. Designed Diblock Oligonucleotide for the Synthesis of Spatially Isolated and Highly Hybridizable Functionalization of DNA–Gold Nanoparticle Nanoconjugates. J. Am. Chem. Soc. 2012, 134, 11876–11879. [Google Scholar] [CrossRef]
- Schreiner, S.M.; Shudy, D.F.; Hatch, A.L.; Opdahl, A.; Whitman, L.J.; Petrovykh, D.Y. Controlled and Efficient Hybridization Achieved with DNA Probes Immobilized Solely through Preferential DNA-Substrate Interactions. Anal. Chem. 2010, 82, 2803–2810. [Google Scholar] [CrossRef]
- Han, W.; Liao, S.; Zhang, C.; Ding, H.; Wu, Z.; Shen, G.; Yu, R. Highly Sensitive Fluorometric Assay Method for Acetylcholine-sterase Inhibitor Based on Nile Red-Adsorbed Gold Nanoparticles. Chin. J. Chem. 2013, 31, 1072–1078. [Google Scholar] [CrossRef]
- Yang, Y.; Mohamed Asiri, A.; Du, D.; Lin, Y. Acetylcholinesterase biosensor based on a gold nanoparticle–polypyrrole–reduced graphene oxide nanocomposite modified electrode for the amperometric detection of organophosphorus pesticides. Analyst 2014, 139, 3055–3060. [Google Scholar] [CrossRef]
- Bai, W.; Zhu, C.; Liu, J.; Yan, M.; Yang, S.; Chen, A. Gold nanoparticle–based colorimetric aptasensor for rapid detection of six organophosphorous pesticides. Environ. Toxicol. Chem. 2015, 34, 2244–2249. [Google Scholar] [CrossRef]
- Parambil, K.; Lisha, A.; Pradeep, T. Enhanced visual detection of pesticides using gold nanoparticles. J. Environ. Sci. Health Part B 2009, 44, 697–705. [Google Scholar]
- Wang, Y.; Zhang, S.; Du, D.; Shao, Y.; Li, Z.; Wang, J.; Englehard, M.; Li, J.; Lin, H. Self Assembly of Ace-tylcholinesterase on a Gold Nanoparticles-Graphene Nanosheet Hybrid for Organophosphate Pesticide Detection Using Polyelectrolyte as a Linker. J. Mater. Chem. 2011, 21, 5319–5325. [Google Scholar] [CrossRef]
- Du, D.; Chen, S.; Cai, J.; Zhang, A. Immobilization of Acetylcholinesterase on Gold Nanoparticles Embedded in Sol-Gel Film for Amperometric Detection of Organo-phosphorous. Biosens. Bioelectron. 2007, 23, 130–134. [Google Scholar] [CrossRef] [PubMed]

| ΔA520 | 5 min | 10 min | 15 min | 20 min | 25 min | 30 min | |
|---|---|---|---|---|---|---|---|
| Pesticides | |||||||
| Ethoprophos | 0.8 mM ATP | 0.154 | 0.257 | 0.366 | 0.427 | 0.459 | 0.499 |
| 1.0 mM ATP | 0.051 | 0.107 | 0.205 | 0.289 | 0.366 | 0.472 | |
| 1.2 mM ATP | 0.026 | 0.077 | 0.140 | 0.196 | 0.244 | 0.304 | |
| 1.4mM ATP | 0.012 | 0.058 | 0.119 | 0.172 | 0.220 | 0.284 | |
| Profenofos | 0.8 mM ATP | ND | 0.025 | 0.039 | 0.048 | 0.056 | 0.061 |
| 1.0 mM ATP | ND | 0.018 | 0.021 | 0.035 | 0.042 | 0.049 | |
| 1.2 mM ATP | ND | ND | ND | 0.015 | 0.023 | 0.030 | |
| 1.4 mM ATP | ND | ND | ND | ND | ND | ND |
| Target Analyte | Detection Technique | Linear Range | Detection Limit | References |
|---|---|---|---|---|
| OPs | Colorimetric/fluorescence | ND | ND | [31] |
| OPs | Fluorescence | ND | 0.05 ng/mL | [40] |
| OPs | Electrochemistry | 0.001–5 μM | 0.5 nM | [41] |
| OPs | Colorimetric | ND | 2 ppm | [42] |
| Chlorpyrifos/malathion | Colorimetric | 100–250 ppb | 20 ppb | [43] |
| OPs | Colorimetric | 80–400 ng/mL | 30 ng/mL | [32] |
| OPs | Colorimetric | 15–65 ppb | 0.7 ppb | [34] |
| Paraoxon | Electrochemistry | ND | 0.1 pM | [44] |
| Monocrotophos | Electrochemistry | ND | 2.7 nM | [45] |
| Ethoprophos | Colorimetric/fluorescence | 4–15 μM | 37 nM | This work |
| Samples | Spike (µM) | Found (µM) | Recovery (%) | RSD (n = 5) a |
|---|---|---|---|---|
| 1 | 4.0 | 4.1 | 102.6% | 3.45% |
| 2 | 8.0 | 8.4 | 105.4% | 0.60% |
| 3 | 10.0 | 10.4 | 103.6% | 0.24% |
© 2018 by the authors. Licensee MDPI, Basel, Switzerland. This article is an open access article distributed under the terms and conditions of the Creative Commons Attribution (CC BY) license (http://creativecommons.org/licenses/by/4.0/).
Share and Cite
Li, X.; Cui, H.; Zeng, Z. A Simple Colorimetric and Fluorescent Sensor to Detect Organophosphate Pesticides Based on Adenosine Triphosphate-Modified Gold Nanoparticles. Sensors 2018, 18, 4302. https://doi.org/10.3390/s18124302
Li X, Cui H, Zeng Z. A Simple Colorimetric and Fluorescent Sensor to Detect Organophosphate Pesticides Based on Adenosine Triphosphate-Modified Gold Nanoparticles. Sensors. 2018; 18(12):4302. https://doi.org/10.3390/s18124302
Chicago/Turabian StyleLi, Xiaoxia, Haixin Cui, and Zhanghua Zeng. 2018. "A Simple Colorimetric and Fluorescent Sensor to Detect Organophosphate Pesticides Based on Adenosine Triphosphate-Modified Gold Nanoparticles" Sensors 18, no. 12: 4302. https://doi.org/10.3390/s18124302
APA StyleLi, X., Cui, H., & Zeng, Z. (2018). A Simple Colorimetric and Fluorescent Sensor to Detect Organophosphate Pesticides Based on Adenosine Triphosphate-Modified Gold Nanoparticles. Sensors, 18(12), 4302. https://doi.org/10.3390/s18124302

